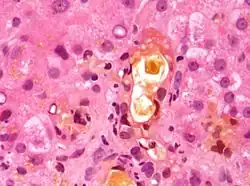

Jaterní testy

Jaterní testy, také známé jako jaterní profil či jaterní panel (anglicky: liver function tests, zkráceně: LFTs) představují základní soubor laboratorních biochemických vyšetření, jejichž cílem je odhalit poškození jater, rozlišit mezi poškozením morfologickým a funkčním, odhadnout závažnost onemocnění a efektivitu nasazené léčby. Pouze na jejich základě však většinou nelze určit, o jaké konkrétní onemocnění jater se jedná a je nutné jejich doplnění dalšími metodami klinické biochemie, konkrétně metodami hematologickými, sérologickými, imunologickými a molekulárně genetickými, stejně tak i metodami zobrazovacími – ultrasonografií, nukleární magnetickou rezonancí a výpočetní tomografií. Zobrazovací metody mohou být spojeny s cílenou biopsií jater a následným histopatologickým vyšetřením.[1][2][3]
Principem jaterních testů je odběr žilní krve, nejčastěji z žil loketní jamky a její odeslání do laboratoře klinické biochemie. V rámci jaterních testů se v krevním vzorku obvykle stanovuje 7 parametrů. Jedná se o alaninaminotransferázu, aspartátaminotransferázu, alkalickou fosfatázu, celkový sérový bilirubin, konjugovaný sérový bilirubin, albumin a celkovou bílkovinu. Velmi často je simultánně (současně) vyžadováno stanovení γ-glutamyltransferázy, laktátdehydrogenázy a protrombinového času.[4]
Struktura a biochemická topografie jater
Pro pochopení podstaty jaterních testů je důležitá znalost histologie jater a enzymatické výbavy jednotlivých typů buněk, které se v játrech nacházejí.
Základní stavební jednotkou jater je jaterní buňka (hepatocyt). Jaterní buňky jsou uspořádány do trámců, skupina trámců pak vytváří lalůček centrální žíly (latinsky: lobulus venae centralis), jež je základní morfologickou jednotkou jater. Jaterní buňky tvoří asi 60 % jaterní tkáně, zbytek připadá na Kupfferovy buňky, Itovy buňky, endotelové buňky, buňky intrahepatálních (nitrojaterních) žlučových cest a extracelulární (mimobuněčnou) tekutinu. Jednotlivé typy buněk plní v játrech, potažmo v organismu, specifické úlohy, čemuž je přizpůsobena jejich struktura a enzymová výbava.[1][5] Pro jaterní buňky, které jsou dobře zásobené kyslíkem, je typická vysoká aktivita enzymu alaninaminotransferázy, aspartátaminotransferázy, laktátdehydrogenázy, gama-glutamyltransferázy a alkalické fosfatázy. Při zhoršeném zásobení kyslíkem mají vysokou aktivitu glutamátdehydrogenázy. Buňky žlučových cest disponují vysokou aktivitou gama-glutamyltransferázy a alkalické fosfatázy. Tyto enzymy lze při poškození daných buněk detekovat v krevní plazmě.[1]
Topografie enzymů v hepatocytu
- v cytoplazmě
- alaninaminotranferáza (ALT)
- aspartátaminotransferáza (cAST) – 60 %, cytoplazmatický izoenzym
- laktádehydrogenáza (LD)
- v mitochondriích
- aspartátaminotransferáza (mAST) – 40 %, mitochondriální izoenzym
- glutamátdehydrogenáza (GMD)
- v membránách endotelu žlučovodů a krevních sinusoidů – enzymy indukující cholestázu
- alkalická fosfatáza (ALP)
- gama-glutamyltransferáza (GMT)
- v lyzozomech – hydrolytické enzymy
- kathepsin
- beta-glukuronidáza (GRS)[6]
Parametry jaterních testů
Podle toho, jakou funkci jater respektive hepatobiliárního systému (z řeckého hepar, tj. játra a latinského bilis, tj. žluč) jednotlivé parametry charakterizují, lze je rozdělit do tří základních skupin (viz tabulka).
| Rozdělení parametrů jaterních testů[7] | ||
|---|---|---|
| Skupina | Funkce | Zkoumaný parametr |
| 1 | laboratorní ukazatelé poškození jaterních buněk | alaninaminotransferáza, aspartátaminotransferáza, laktátdehydrogenáza |
| 2 | laboratorní ukazatelé městnání žluči v játrech | alkalická fosfatáza, celkový bilirubin v séru, konjugovaný bilirubin v séru, γ-glutamyltransferáza |
| 3 | laboratorní ukazatelé proteosyntetické funkce jater | albumin, celková bílkovina, protrombinový čas |
Laboratorní ukazatelé poškození jaterních buněk
Při hepatocelulárním poškození se z hepatocytů do krve nadměrně uvolňují některé enzymy. Jejich zvýšenou aktivitu v krevní plazmě lze následně biochemicky prokázat. Je-li poškozena pouze cytoplazmatická membrána hepatocytu, uvolňují se do krve především enzymy lokalizované v cytoplazmě, tj. alaninaminotransferáza (ALT), cytoplazmatický izoenzym aspartátaminotransferázy (cAST) a jaterní izoenzym laktátdehydrogenázy (LD5). Při těžším poškození hepatocytů, kdy jsou zasaženy i mitochondrie, se do krve dostávají jednak ALT, cAST a LD5, jednak enzymy lokalizované v mitochondriích, tj. mitochondriální izoenzym aspartátaminotransferázy (mAST) a glutamátdehydrogenáza (GMD).[7][8] Nejcitlivějšími indikátory morfologického poškození jater jsou aminotransferázy.[9] O poruše funkce jater nás však tyto enzymy neinformují.[1]
Aminotransferázy (starší název: transaminázy) jsou enzymy katalyzující transaminační reakce, tedy vratné (reverzibilní) reakce, při kterých dochází k přenosu aminoskupiny (NH2) z aminokyseliny (AMK1) na α-oxokyselinu (OK1) za vzniku jiné aminokyseliny (AMK2) a jiné α-oxokyseliny (OK2). Kofaktorem reakce je pyridoxal-5’-fosfát (P-5’-P).[10][11] Transaminační reakce je první reakcí, jíž v procesu degradace podléhají aminokyseliny pocházející z bílkovin potravy i aminokyseliny pocházející z nitrobuněčných bílkovin. Její podstatou je odstranění aminoskupiny z aminokyseliny. Uhlovodíkový řetězec zbylý z aminokyseliny je degradován dalšími procesy.[10]
Jelikož transaminační reakce jsou vratné, aminotransferázy se uplatňují nejen v degradaci (katabolismu) aminokyselin, ale i v jejich biosyntéze (anabolismu).[10] Nejdůležitějšími aminotransferázami v klinické medicíně jsou alaninaminotransferáza a aspartátaminotransferáza.[12]
Alaninaminotransferáza
| Norma |
| dospělí: 0,1–0,78 µkat/l |
Alaninaminotransferáza (zkráceně ALT, starší název: glutamát-pyruvát transamináza, zkráceně GPT) je cytoplazmatický enzym vysoce specifický pro jaterní buňku. V mnohem menší míře se nachází např. v myokardu nebo kosterním svalu. Funkcí ALT je katalýza transaminační reakce, při které dochází k přenosu aminoskupiny z alaninu na 2-oxoglutarát za vzniku pyruvátu a glutamátu. Kofaktorem reakce je pyridoxal-5’-fosfát.[7] Při mírném poškození jaterní buňky při zvýšení propustnosti (permeability) cytoplazmatické membrány se ALT dostává do krve ve zvýšené míře. Průkaz zvýšené katalytické koncentrace ALT v krevním séru je velmi specifickým ukazatelem poškození jaterní buňky.[8][9]
Fyziologická hodnota ALT v krevním séru dospělého jedince je 0,1–0,78 µkat/l.[13]
Aspartátaminotransferáza
| Norma |
| dospělí: 0,05–0,72 µkat/l |
Aspartátaminotransferáza (zkráceně AST, starší název: glutamát-oxalacetát transamináza, zkráceně GOT) je enzym katalyzující transaminační reakci, při které dochází k přenosu aminoskupiny z aspartátu na 2-oxoglutarát za vzniku oxalacetátu a glutamátu.[7] AST je lokalizovaná v cytoplazmě i v mitochondriích jaterních buněk.

Rozlišujeme tedy dvě izoformy – cytoplazmatickou a mitochondriální. AST není specifická jen pro játra, vyskytuje se v celé řadě dalších tkání (ledviny, srdeční sval, kosterní sval, mozek, slinivka břišní, červené krvinky). Cytoplazmatický izoenzym AST se dostává do krve, stejně jako ALT, i při jen lehkém postižení jaterních buněk (při zvýšené propustnosti cytoplazmatické membrány jaterní buňky). Mitochondriální izoenzym AST se uvolňuje do krve až při rozpadu (nekróze) jaterních buněk.[2][8] Fyziologická hodnota AST v krevní séru dospělého jedince je 0,05–0,72 µkat/l.[14] Výraznější zvýšení katalytické koncentrace AST je prognosticky závažnější než zvýšení ALT, protože signalizuje uvolnění cytoplazmatické i mitochondriální frakce, a tudíž rozpad jaterních buněk. Koncentrace AST může být zvýšena i u nemocí krve, ledvin, srdce, kosterních svalů či slinivky břišní.[2]
Výrazné zvýšení aminotransferáz (3–20násobné[2]) bývá u toxického/alkoholového poškození jater, akutní i chronické hepatitidy, biliární koliky či pravostranného srdečního selhání. Mírnější zvýšení může doprovázet jaterní cirhózu, jaterní steatózu, nealkoholovou jaterní steatohepatitidu, chronickou hepatitidu, cholestatická onemocnění jater, nádory jater.[2][9][15] Ke zvýšení aminotransferáz může dojít i při intenzivní fyzické námaze, nemocech svalů nebo při užívání některých léků (např. antibiotika erytromycinu).[9]
De Ritisův koeficient
De Ritisův koeficient (de Ritisův index, de Ritisův kvocient) je poměr AST/ALT, který slouží k rozlišení poškození zánětlivého a nekrotického charakteru.[2][9]
- Kvocient pod 1 (ALT > AST) je typický pro poškození zánětlivé, např. virové hepatitidy. Dojde-li však k progresi virové hepatitidy do stádia jaterní cirhózy, de Ritisův kvocient stoupne nad 1. Poměr AST/ALT pod 1 bývá také u pacientů s pravostranným srdečním selháním, u kterých dochází k městnání krve v játrech.[16]
- Kvocient nad 1 (AST > ALT) je typický pro poškození nekrotické.
- Kvocient nad 2 (AST >> ALT) se velmi často vyskytuje u pacientů s alkoholovými jaterními chorobami. Obecně platí, že čím vyšší je hodnota AST, tím je poškození jater závažnější a prognóza méně příznivá.
Laktátdehydrogenáza
| Norma |
| muž: 2,2–3,8 µkat/l |
| žena: 2,2–3,6 µkat/l |
Laktátdehydrogenáza (zkráceně LD nebo LDH) je enzym katalyzující přeměnu laktátu na pyruvát, tj. poslední krok spalování glukózy za nepřítomnosti kyslíku (anaerobní glykolýza).[10] Rozlišujeme 5 forem tohoto enzymu, tj. 5 izoenzymů (LD1, LD2, LD3, LD4, LD5), které se nacházejí v buňkách různých tkání. Pro játra a kosterní svaly je specifický izoenzym LD4 a LD5.[17] I když není laktátdehydrogenáza součástí klasického jaterního panelu, stanovení jejího izoenzymu LD5 může v některých případech napomoci v diagnostice nádorového postižení jater.[9]
Fyziologická hodnota koncentrace LD v krevním séru dospělého muže je 2,2–3,8 µkat/l, u dospělé ženy pak 2,2–3,6 µkat/l.[17]
Laboratorní ukazatelé městnání žluči v játrech
K městnání žluči v játrech (odborně cholestáze) dochází nejčastěji v důsledku blokády (obstrukce) žlučových cest konkrementem (nepřesně žlučovým kaménkem) nebo nádorem. Dále může cholestáza vzniknout na podkladě zánětu, dědičných poruch či působením některých léků.
Blokáda žlučových cest znemožňuje odtok žluči z jater do střeva, žluč se hromadí před překážkou (konkrement, nádor) a ve žlučových cestách roste tlak, který poškozuje výstelku (endotelové buňky) žlučových cest i jaterní buňky. Z takto poškozovaných buněk se zvýšeně uvolňují enzymy, z nichž klinicko-biochemicky nejdůležitější jsou alkalická fosfatáza a γ-glutamyltransferáza. Hromadění žluči před blokádou má za následek zvýšení koncentrace bilirubinu v séru.
Alkalická fosfatáza

Alkalická fosfatáza (zkráceně ALP, další název: alkalifosfatáza) je enzym s nízkou substrátovou specificitou patřící do skupiny hydroláz. Katalyzuje hydrolýzu fosfátových esterů v alkalickém prostředí.[19] V několika izoformách (jaterní, kostní, střevní, placentární, …) se nachází ve všech buňkách lidského organismu.[7] U zdravých jedinců je sérová koncentrace ALP podmíněna především její jaterní a kostní izoformou. U dospělých jedinců převládá jaterní forma, u dětí (období růstu) převládá kostní izoforma.[2]
| Norma |
| dospělí: 0,66–2,2 µkat/l |
Fyziologická hodnota koncentrace ALP v krevním séru dospělého jedince je 0,66–2,2 µkat/l.[20] Zvýšené hodnoty doprovázejí především intrahepatální a extrahepatální cholestázu (městnání žluči v játrech a mimojaterních žlučových cestách). Mezi další stavy zvyšující sérovou koncentraci ALP patří například nemoci kostí, nádory kostí a jater včetně jejich metastatického postižení, revmatologické choroby či zvýšená funkce příštitných tělísek (hyperparatyreóza).[21]
Gama-glutamyltransferáza
| Norma |
| muž: 0,14–0,84 µkat/l |
| žena: 0,14–0,68 µkat/l |
Gama-glutamyltransferáza (γ-glutamyltransferáza, γ-glutamyltranspeptidáza, zkráceně GGT nebo γGT) je enzym fyziologicky přítomný v membránách buněk s vysokou sekreční nebo absorpční aktivitou (játra, slinivka břišní, slezina, ledviny, prostata, srdce, mozek, placenta). V játrech se nachází v membráně jaterních buněk a v membráně buněk vystýlajících žlučové cesty (endotelové buňky žlučových cest).
Funkcí GGT je katalýza přenosu γ-glutamylové skupiny na vodu, peptid nebo aminokyselinu; GGT hraje důležitou roli v γ-glutamylovém cyklu a metabolismu glutathionu.[2][22][23][24]
Fyziologická hodnota koncentrace GGT v krevním séru dospělého muže je 0,14–0,84 µkat/l, u dospělé ženy pak 0,14–0,68 µkat/l.[25] GGT se stanovuje většinou společně s ALP při podezření na onemocnění hepatobiliárního systému (jater a žlučových cest). Zvýšené sérové koncentrace nacházíme při městnání žluči v játrech, při akutních i chronických onemocnění jater včetně nádorů jater a při poškození jater dlouhodobým užíváním alkoholu. Hladina GGT však může stoupat i při některých mimojaterních onemocněních (infarkt myokardu, cukrovka, nádory slinivky břišní, chronická obstrukční bronchopulmonální nemoc apod.)[7][8][23]; také kuřáci a obézní jedinci mohou mít GGT nad horní hranicí normy.[2]
Bilirubin

Bilirubin je žlučové barvivo. Vzniká degradací červeného krevního barviva (hemoglobinu) pocházejícího z rozpadlých červených krvinek. Degradace hemoglobinu se odehrává v buňkách retikuloendotelového systému, což je systém fagocytujících buněk vyskytujících se především v játrech, slezině a lymfatické tkáni. V malém množství vzniká bilirubin i z jiných hemoproteinů (např. z myoglobinu, cytochromů, katalázy).[27]

Lidský organismus denně vytvoří cca 300 mg bilirubinu.[28] Vzniklý bilirubin je krví transportován do jater, kde dochází k jeho konjugaci („spojení“) s kyselinou glukuronovou pomocí enzymu UDP-glukosiduronáttransferázy, čímž vzniká bilirubinmonoglukosiduronát a bilirubindiglukosiduronát. Konjugace bilirubinu je proces, kterým se bilirubin stává rozpustným ve vodě. Ve vodě rozpustná forma bilirubinu se označuje termínem konjugovaný (přímý) bilirubin. Konjugovaný bilirubin (bilirubindiglukosiduronát) je jakožto součást žluče transportován z jater žlučovými cestami do tenkého střeva. V zažívacím traktu je bilirubin dekonjugován, vzniká tak nekonjugovaný (nepřímý) bilirubin, který je dále degradován (redukován).
Nejdůležitějším degradačním (redukčním) produktem bilirubinu je urobilinogen. Konjugovaný bilirubin a urobilinogen mohou za určitých podmínek podléhat enterohepatálnímu oběhu, tzn. že se ze střeva vstřebají do krve a krví se vrátí zpět do jater.[2][29]
| Norma |
| dospělí: 2,0–17,0 µmol/l |
Laboratorní stanovení koncentrace bilirubinu v krevním séru je důležitým testem, který informuje lékaře o rozpadu červených krvinek, funkčním stavu jater a průchodnosti žlučových cest.[30] Současně lze testovat i přítomnost konjugovaného bilirubinu a urobilinogenu v moči.[29] Fyziologická koncentrace celkového bilirubinu (konjugovaného i nekonjugovaného) v krevním séru dospělého jedince činí 2,0–17,0 µmol/l.[31] Fyziologická koncentrace konjugovaného bilirubinu v krevním séru dospělého jedince činí 0,0–5,1 µmol/l.[32] Zvýšení bilirubinu v krevním séru nad 17 µmol/l se označuje jako hyperbilirubinémie. Při zvýšení nad 35 µmol/l bilirubin přestupuje z krve do tkání (sliznice, kůže, oční spojivka) a způsobuje jejich žlutavé zbarvení. Pro tento stav je vyčleněn termín žloutenka neboli ikterus. Ikterus je důležitým příznakem jaterních i některých mimojaterních onemocnění. Kromě zežloutnutí je často přítomna i změna barvy stolice a moči.[8][9]
Klinická medicína rozlišuje 3 základní typy ikteru:[30][33]
- Prehepatální ikterus (hemolytický). Problém/porucha způsobující prehepatální ikterus se nachází „před játry“ (z latinského prae, tj. před a řeckého hepar, tj. játra). Nejčastěji se jedná o nadměrný rozpad červených krvinek (nadměrná hemolýza). Koncentrace nekonjugovaného bilirubinu v séru je zvýšena. Stolice je tmavá (hypercholická). V moči lze prokázat urobilinogen. Nekonjugovaný bilirubin neprostupuje přes glomerulární membránu v ledvinách, do moči se tudíž nedostává. Barva moči je normální. Ostatní parametry jaterních testů jsou v normě.[28][34]
- Hepatocelulární ikterus (hepatální, parenchymatózní). Problém/porucha způsobující hepatocelulární ikterus se nachází „v játrech“ samotných (z řeckého hepar, tj. játra a latinského cellula, tj. buňka). Hepatocelulární poškození může vzniknout např. při virových zánětech jater (virové hepatitidy), nadměrné konzumaci alkoholu, ischémii, autoimunitních poruchách, konzumaci drog a jiných chemikálií. Na úrovni jaterní buňky je porušena konjugace bilirubinu i jeho vylučování na žlučovém pólu hepatocytu. V séru stoupá hladina konjugovaného i nekonjugovaného bilirubinu. Stolice je světlá (hypocholická). V moči lze prokázat urobilinogen i bilirubin (konjugovaná frakce bilirubinu je ve vodě rozpustná, v ledvinách prostupuje přes glomerulární membránu a do moči se dostává). Barva moči je tmavá.[28][34] Laboratorně dojde také ke zvýšení koncentrací aminotransferáz (ALT, AST). Alkalická fosfatáza je v normě.[35]
- Posthepatální ikterus (obstrukční, cholestatický). Problém/porucha způsobující posthepatální ikterus se nachází „za játry“ (z latinského post, tj. za a řeckého hepar, tj. játra). Vzniká jako následek poruchy vylučování konjugovaného bilirubinu do střeva (žluč se v důsledku překážky nedostává žlučovými cestami do střeva). Překážka znemožňující tok žluči do střeva může být lokalizována v játrech (intrahepatální cholestáza) nebo ve žlučových cestách mimo játra (extrahepatální cholestáza). Příčinou intrahepatální cholestázy je např. onemocnění zvané primární biliární cirhóza. Příčinou extrahepatální cholestázy je nejčastěji uzávěr žlučových cest konkrementem nebo stlačení (komprese) žlučových cest zhoubným nádorem slinivky břišní (hlava slinivky břišní „sousedí“ se žlučovými cestami). V séru je zvýšena hladina konjugovaného bilirubinu. Konjugovaný bilirubin lze prokázat i v moči, moč má tmavou barvu. Při úplné neprůchodnosti (obstrukci) žlučových cest se do střeva nedostává žádná žluč, stolice je odbarvená (acholická), urobilinogen nevzniká a v moči je tedy negativní.[34][35] Alkalická fosfatáza a gama-glutamyltransferáza jsou zvýšené.[9]
Laboratorní ukazatelé proteosyntetické funkce jater
Játra jsou místem tvorby celé řady bílkovin (albumin, ceruloplazmin, haptoglobin, transferin, alfa-1-antitrypsin, lipoproteiny, faktory srážení krve), které jsou následně z jater uvolňované do krevního oběhu. Schopnost jater „vyrábět“ bílkoviny (syntetizovat proteiny) se odborně označuje jako tzv. proteosyntetická funkce jater. Při některých jaterních onemocněních (např. jaterní cirhóze) je tato funkce jater poškozena – játra pracují nedostatečně, „vyrábějí“ a do krevního oběhu uvolňují menší množství bílkovin než za fyziologického (normálního) stavu. Snížené hodnoty albuminu a celkové bílkoviny v krevním séru tak poukazují na sníženou tvorbu bílkovin v játrech, potažmo na poškození jater.[2][36]
Albumin
| Norma |
| dospělí: 35–53 g/l |
Albumin je hlavní bílkovinou lidské krve. Název albuminu pochází z latinského albus, tj. bílý (podle flokulujících precipitátů albuminu majících bílou barvu).[37] Je syntetizován (tvořen) v játrech v denním množství 12–15 g.[2] Jedná se o důležitou bílkovinu lidského organismu, která udržuje pH[37] a onkotický tlak krevní plazmy a zajišťuje transport celé řady látek (kupř. hořčíku, vápníku, mastných kyselin, bilirubinu, hormonů, léků).[10][38] Stanovení koncentrace albuminu v krevním séru umožňuje odhadnout schopnost jater syntetizovat (tvořit, „vyrábět“) bílkoviny.[36]
Fyziologická koncentrace sérového albuminu je 35–53 g/l.[38] Sérová hladina albuminu je ovlivňována jeho syntézou, distribucí a degradací, nutričním stavem, osmotickým tlakem i hormonálně (růstový hormon, kortikoidy, inzulin, glukagon, thyroxin). Dehydratovaní pacienti a pacienti léčeni diuretiky mohou mít hladinu albuminu zvýšenou. Snížená hodnota sérového albuminu může signalizovat jaterní onemocnění, onemocnění ledvin, popáleniny, protein-ztrácející enteropatii (exudativní gastroenteropatie), malabsorpci, nedostatečný přísun bílkovin stravou, zánětlivé onemocnění aj.[15] Hladina albuminu v séru dobře koresponduje s prognózou jaterních onemocnění – pokles pod 30 g/l bývá velmi vážný. Při akutních jaterních nemocech je hladina albuminu normální, neboť poločas albuminu je přibližně 19 dní.[9][37]
Celková bílkovina
Celková bílkovina je souborné označení pro bílkoviny nacházející se v krevní plazmě (odborně plazmatické proteiny). Jedná se o bílkoviny s různou strukturou i funkcí (transport látek, obrana proti infekci, srážení krve apod.); většina těchto bílkovin je tvořena játry a lymfocyty. Stanovení celkové bílkoviny v krevním séru je běžná metoda dávající orientační informaci o tvorbě, užití a vylučování bílkovin v lidském organismu.[8] Velká škála onemocnění může být příčinou změn ve složení plazmatických bílkovin, ale jen některé změny se projeví snížením nebo zvýšením hodnot celkové bílkoviny.[39] Nejčastěji se koncentrace celkové bílkoviny stanovuje při podezření na podvýživu, zánět, onemocnění ledvin, jater nebo krve.[40]
Fyziologická koncentrace celkové bílkoviny v krevním séru u dospělého jedince je 65–85 g/l.[40]
Protrombinový čas

Koagulační faktory I, II, V, VII, IX a X jsou tvořeny v játrech. Syntéza faktorů II, VII, IX a X je závislá na vitaminu K. Nemoci jater doprovázené sníženou proteosyntetickou funkci jater i obstrukční ikterus mohou být příčinou snížené koncentrace těchto faktorů v krevním séru a poruchy koagulace. V případě nemocí jater dochází k nedostatečné tvorbě koagulačních faktorů, v případě obstrukčního ikteru je narušeno vstřebávání tuků a v tucích rozpustných vitaminů, mezi něž patří i vitamin K.[15]
Citlivým ukazatelem jaterního poškození je v těchto případech protrombinový čas (Quickův test, zkráceně PT nebo INR), Quickův test zachycuje aktivitu zevního koagulačního systému, jeho biochemickou podstatou je měření přeměny (konverze) protrombinu na trombin za přítomnosti tkáňového tromboplastinu a Ca2+.[2] Fyziologická hodnota je 12–15 s[9]; výsledek vyšetření se udává jako tzv. INR (z anglického international normalized ratio), což je poměr vyšetřovaného protrombinového času ku kontrolnímu normálnímu vzorku.[2] Jelikož má protrombin krátký poločas, lze stanovení protrombinového času využít i v diagnostice akutních jaterních nemocí (např. akutní hepatodystrofie) či progrese chronických jaterních onemocnění do jaterního selhání.[9][42]
| Norma |
| dospělí: 0,75–1,25 |
Fyziologická hodnota (INR) je 0,75–1,25.[43] Kromě nemocí jater a nedostatku vitaminu K může zvýšená hodnota signalizovat diseminovanou intravaskulární koagulopatii, vrozený deficit koagulačních faktorů, léčbu některými léky (př. warfarin, antibiotika).[43] Stanovení protrombinového času má i spoustu dalších indikací (př. krvácivé stavy, monitorování pacientů léčených warfarinem), je součástí předoperačního vyšetření, v případě jaterních onemocnění má i prognostický význam.[9][44]
Odkazy
Reference
- ↑ a b c d RACEK, Jaroslav, et al. Klinická biochemie. Praha: Galén, 2006. 329 s. ISBN 80-7262-324-9.
- ↑ a b c d e f g h i j k l m n ZIMA, Tomáš, et al. Laboratorní diagnostika. Praha: Galén, 2009. 906 s. ISBN 978-80-7262-372-3.
- ↑ HOŘEJŠÍ, Jaroslav, et al. Základy klinické biochemie ve vnitřním lékařství. Praha: Avicenum, 1989. 724 s. Kapitola III. Játra a žlučové cesty, s. 97–178.
- ↑ Lab Tests Online: Jaterní profil [online]. C2001-2010, rev. 2010-10-08 [cit. 2011-08-14]. Dostupné v archivu pořízeném dne 2016-03-27.
- ↑ KONRÁDOVÁ, Václava; UHLÍK, Jiří; VAJNER, Luděk. Funkční histologie. Jinočany: H+H, 2000. 290 s. ISBN 80-86022-80-3. Kapitola Trávicí systém, s. 179–185.
- ↑ MASOPUST, Jaroslav. Požadování a hodnocení biochemických vyšetření I. část. Praha: Avicenum, 1991. 328 s. ISBN 80-85047-04-7. S. 109–112.
- ↑ a b c d e f FIALOVÁ, Lenka; VEJRAŽKA, Martin. Játra a vybraná biochemická vyšetření u jaterních onemocnění [online]. Praha: Ústav lékařské biochemie 1. lékařské fakulty UK, 2005. Dostupné online.
- ↑ a b c d e f FELDAMAN, Mark; SCHARSCHMIDT, Bruce F.; SLEISENGER, Marvin H. Sleisenger and Fordtran's Gastrointestinal and Liver Disease: Pathophysiology/Diagnosis/Management. Philadelphia: Saunders, 1998. 2046 s. Dostupné online. ISBN 978-0721662916. (anglicky)
- ↑ a b c d e f g h i j k l BRODANOVÁ, Marie. Hepatologie v praxi. Praha: Galén, 1997. 389 s. ISBN 80-85824-47-7. Kapitola 4, s. 40–69.
- ↑ a b c d e MURRAY, Robert K.; BENDER, David A.; BOTHAM, Kathleen M., et al. Harper's Illustrated Biochemistry. 28. vyd. USA: McGraw-Hill Medical, 2009. 704 s. ISBN 978-0071625913. Kapitola Metabolism of proteins & amino acids, s. 234–285. (anglicky)
- ↑ OSHIMA, T; TAMIYA. Mechanism of Transaminase Action. S. 116–119. Biochem. J. [online]. 1961. Čís. 78, s. 116–119. Dostupné online. ISSN 0264-6021.
- ↑ LEDVINA, Miroslav; STOKLASOVÁ, Alena; CERMAN, Jaroslav. Biochemie pro studující medicíny: I. díl. Praha: Karolinum, 2006. 274 s. ISBN 80-246-0849-9. Kapitola Degradace bílkovin a metabolismus aminokyselin, s. 223–225.
- ↑ KOTAČKOVÁ, Lenka. Top Lékař: Laboratorní hodnoty. Alaninaminotransferáza [online]. C2011 [cit. 2011-08-14]. Dostupné v archivu pořízeném dne 2011-03-22.
- ↑ KOTAČKOVÁ, Lenka. Top Lékař: Laboratorní hodnoty. Aspartátaminotransferáza [online]. C2011 [cit. 2011-08-14]. Dostupné v archivu pořízeném dne 2013-04-29.
- ↑ a b c SCHNEIDERKA, Petr. Vybrané kapitoly z klinické biochemie. Praha: Karolinum, 1998. 119 s. ISBN 80-7184-505-1. Kapitola Biochemické vyšetřovací metody v hepatologii.
- ↑ ASCHERMANN, Michael, et al. Kardiologie. Praha: Galén, 2004. 1540 s. ISBN 80-7262-290-0.
- ↑ a b KOTAČKOVÁ, Lenka. Top Lékař: Laboratorní hodnoty. Laktátdehydrogenáza [online]. C2011 [cit. 2011-08-15]. Dostupné v archivu pořízeném dne 2014-01-21.
- ↑ Wikipedia contributors. Feathery degeneration [online]. Wikipedia, The Free Encyclopedia, rev. 2010-04-14 [cit. 2011-08-18]. Dostupné online. (anglicky)
- ↑ MARSHALL, Kaplan M. Alkaline Phosphatase. N Engl J Med. Roč. 1972, čís. 286, s. 200–202. ISSN 0028-4793.
- ↑ KOTAČKOVÁ, Lenka. Top Lékař: Laboratorní hodnoty. Alkalická fosfatáza [online]. C2011 [cit. 2011-08-17]. Dostupné v archivu pořízeném dne 2012-01-25.
- ↑ EPSTEIN, E., et al. The clinical use of alkaline phosphatase enzymes. S. 491–505. Clin Lab Med [online]. 1986. Roč. 6, čís. 3, s. 491–505. PMID 3527542. (anglicky)
- ↑ GOLDBERG, D.M. Structural, functional, and clinical aspects of gamma-glutamyltransferase. S. 1–58. CRC Crit Rev Clin Lab Sci [online]. 1980. Roč. 12, čís. 1, s. 1–58. PMID 6104563. (anglicky)
- ↑ a b WHITFIELD, J.B. Gamma glutamyl transferase. S. 263–355. Crit Rev Clin Lab Sci [online]. 2001. Roč. 38, čís. 4, s. 263–355. PMID 11563810. (anglicky)
- ↑ HAN, L., et al. Design, synthesis, and evaluation of gamma-phosphono diester analogues of glutamate as highly potent inhibitors and active site probes of gamma-glutamyl transpeptidase. S. 1432–47. Biochemistry [online]. 2007. Roč. 46, čís. 5, s. 1432–47. PMID 17260973. (anglicky)
- ↑ KOTAČKOVÁ, Lenka. Top Lékař: Laboratorní hodnoty. Gama-glutamyltransferáza [online]. C2011 [cit. 2011-08-16]. Dostupné v archivu pořízeném dne 2016-03-04.
- ↑ DRAKE, Richard; VOGL, Wayne; MITCHELL, Adam. Gray's Anatomy for Students. [s.l.]: Churchill Livingstone, 2004. 1150 s. ISBN 978-0443066122. (anglicky)
- ↑ EHRMANN, Jiří; PROCHÁZKA, Vlastimil; SCHNEIDERKA, Petr. Diferenciální diagnostika ikteru. Postgraduální medicína [online]. 2001 [cit. 2011-09-05]. Čís. 8. Dostupné v archivu pořízeném z originálu dne 2020-06-17. ISSN 1212-4184.
- ↑ a b c EHRMANN, Jiří; KRTEK, Vladislav. Ikterus - diferenciální diagnostika [online]. Česká lékařská společnost Jana Evangelisty Purkyně, 2002 [cit. 2011-09-05]. Dostupné v archivu pořízeném dne 2011-08-23.
- ↑ a b SHERLOCK, Sheila; DOOLEY, James. Diseases of the Liver & Biliary System. 11. vyd. [s.l.]: Wiley-Blackwell, 2002. 728 s. ISBN 978-0632055821. (anglicky)
- ↑ a b FIALOVÁ, Lenka; VEJRAŽKA, Martin. Žlučová barviva [online]. Praha: Ústav lékařské biochemie 1. lékařské fakulty Univerzity Karlovy, 2005. Dostupné online.
- ↑ KOTAČKOVÁ, Lenka. Top Lékař: Laboratorní hodnoty. Bilirubin celkový [online]. C2011 [cit. 2011-09-05]. Dostupné v archivu pořízeném dne 2013-04-29.
- ↑ KOTAČKOVÁ, Lenka. Top Lékař: Laboratorní hodnoty. Bilirubin přímý [online]. C2011 [cit. 2011-09-05]. Dostupné v archivu pořízeném dne 2016-03-04.
- ↑ WINGER, J.; MICHELFELDER, A. Diagnostic approach to the patient with jaundice. S. 469–82. Prim Care [online]. 2011. Roč. 38, čís. 3, s. 469–82. PMID 21872092. (anglicky)
- ↑ a b c ROCHE, Sean P.; KOBOS, Rebecca. Jaundice in the adult patient. S. 299–304. Am Fam Physician [online]. 2004. Roč. 69, čís. 2, s. 299–304. Dostupné online. PMID 14765767. (anglicky)
- ↑ a b KRÁL, Vladimír. Obstrukční ikterus [online]. Česká chirurgická společnost ČLS JEP, 2001 [cit. 2011-09-08]. Dostupné v archivu pořízeném dne 2011-05-25.
- ↑ a b FRIEDMAN, Lawrence S.; KEEFFE, Emmet B. Handbook of Liver Disease. 2. vyd. USA: Churchill Livingstone, 2004. 496 s. Dostupné online. ISBN 978-0443066337. (anglicky)
- ↑ a b c Advances in protein chemistry: Lipoproteins, Apolipoproteins, and Lipases. Příprava vydání Verne N. Schumaker. San Diego: Academic Press, 1994. 464 s. Dostupné online. ISBN 978-0120342457. Kapitola Structure of serum albumin, s. 153-196. (anglicky)
- ↑ a b KOTAČKOVÁ, Lenka. Top Lékař: Laboratorní hodnoty. Albumin [online]. C2011 [cit. 2011-09-13]. Dostupné v archivu pořízeném dne 2011-03-22.
- ↑ FIALOVÁ, Lenka; VEJRAŽKA, Martin. Bílkoviny. Základní biochemická vyšetření bílkovin v séru a moči. [online]. Praha: Ústav lékařské biochemie 1. lékařské fakulty UK, 2005. Dostupné online.
- ↑ a b KOTAČKOVÁ, Lenka. Top Lékař: Laboratorní hodnoty. Celková bílkovina v séru [online]. C2011 [cit. 2011-09-19]. Dostupné v archivu pořízeném dne 2013-04-29.
- ↑ HUANG, M., et al. Structural basis of membrane binding by Gla domains of vitamin K-dependent proteins\. S. 751–6. Nat Struct Biol [online]. 2003. Roč. 10, čís. 9, s. 751–6. Dostupné online. ISSN 1072-8368. PMID 12923575.
- ↑ BELLEST, Laurent, et al. A modified international normalized ratio as an effective way of prothrombin time standardization in hepatology. S. 528–534. Hepatology [online]. 2007. Roč. 46, čís. 2, s. 528–534. Dostupné online. ISSN 1527-3350. doi:10.1002/hep.21680. PMID 17654598.
- ↑ a b KOTAČKOVÁ, Lenka. Top Lékař: Laboratorní hodnoty. Protrombinový čas [online]. C2011 [cit. 2011-09-13]. Dostupné v archivu pořízeném dne 2016-03-04.
- ↑ SUCHMAN, A.L.; GRINER, P.F. Diagnostic uses of the activated partial thromboplastin time and prothrombin time. S. 810–6. Ann Intern Med [online]. 1986. Roč. 104, čís. 6, s. 810–6. ISSN 1539-3704. PMID 3706933.
Literatura
- SWANSON, Todd A.; KIM, Sandra I.; GLUCKSMAN, Marc J., et al. BRS Biochemistry, Molecular Biology, and Genetics. 5. vyd. USA: Lippincott Williams & Wilkins, 2010. Dostupné online. ISBN 978-0781798754. (anglicky)
- TARGHER, G. Elevated serum gamma-glutamyltransferase activity is associated with increased risk of mortality, incident type 2 diabetes, cardiovascular events, chronic kidney disease and cancer - a narrative review. S. 147–57. Clin Chem Lab Med [online]. 2010. Roč. 48, čís. 2, s. 147–57. PMID 19943812. (anglicky)
Externí odkazy
 Obrázky, zvuky či videa k tématu jaterní testy na Wikimedia Commons
Obrázky, zvuky či videa k tématu jaterní testy na Wikimedia Commons